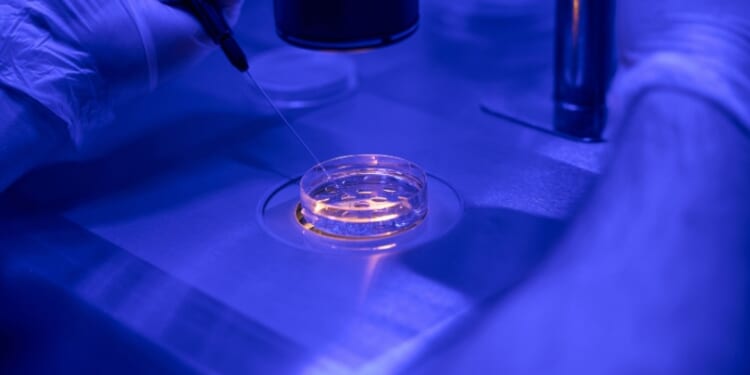
'Brave New World': IVF company’s eugenics tool lets couples pick ‘best’ baby, discard the rest

(LifeSiteNews) — “Pick your baby.” The invitation is now not just for little girls choosing their baby doll or for “Sims” gamers. It is the draw for real-life couples trying to conceive a baby through in-vitro fertilization (IVF) to the company Nucleus IVF+, which has chosen that unsettling invitation for their marketing campaign and URL: www.pickyourbaby.com.
Couples who sign up with Nucleus IVF+ are presented with an electronic “menu” of up to 20 embryos they have conceived, allowing them to view the sex of each baby, their anticipated hair and eye color, and predictions about the height and IQ of each as well as their risk for various diseases. The company notes that all these characteristics are only framed in terms of probabilities — they cannot make any guarantees.
The process nevertheless allows a couple to maximize their chances of having an “ideal” child. The technology goes above and beyond traditional IVF disease screening by looking not only at debilitating and deadly diseases but more “ordinary” problems like risk for hypertension, diabetes, prostate cancer, and even male pattern baldness.
Every parent wants to give their children more than they had. For the first time in human history, Nucleus adds a new tool to that commitment.
Welcome to Nucleus Embryo.https://t.co/jQd8SCVJaP
— Nucleus Genomics (@nucleusgenomics) June 4, 2025
To shed light on the “why” behind the tool, company founder Kian Sadeghi described parents’ desires for their children: “They want us to, you know, play sports and they want us to go to the best school. They want us to be well educated. They want us to thrive. Life, I think, as a parent doesn’t just stop at ‘I want my child to be healthy,’” Sadeghi told CBS News in December.
New York City subways have recently been plastered with ads for Nucleus IVF+, luring potential customers with the reminder that “IQ is 50% genetic,” “Height is 80% genetic,” and with the promise of being able to “have a healthier baby,” or simply “have your best baby.”
A Brave New World is getting eerily close.
Of course, IVF already involves gravely immoral practices, not least of which is the deliberate killing of “excess” embryos. Once you pick your “best baby” (Nucleus’ own marketing phrase), the rest of your embryonic-stage babies are discarded like trash, as is standard in IVF practice. This itself is objectively evil and dystopian. “Pick your baby” then is an Orwellian euphemism for selecting the genetically “fit” and killing the rest of your offspring.
What distinguishes Nucleus IVF is that it layers on another serious ethical problem through its clear practice of eugenics. Sadeghi has defended Nucleus IVF+ against this accusation, claiming it is not eugenics “by any stretch because it’s fundamentally about empowering people with information that they can use to give their child the best start in life.” He added, “And yes, if you want two inches taller for your child, three inches taller, right, if you want a couple IQ-point difference, absolutely, by all means, do that.”
However, this IVF practice, which literally kills off “less desirable” embryonic humans to favor the “ideal” child by the parents’ own standards, is eugenic by definition. Eugenics may involve different practices, including abortion, selective breeding, or sterilization, but these all fall under the umbrella of interventions aimed at improving the “genetic quality” of human beings. This is exactly what Nucleus IVF+ does.
Nucleus IVF+ is enticing to couples already seeking conception through IVF because it seems innocent. Most selected traits involve disease risk, so its emphasis appears to be on the well-being of the child. Traits like IQ, risk-taking, and height are swept under this justification — adjusting any of these factors will presumably make a child better off.
The technology opens the door to even bigger problems for a reason articulated by Sadeghi himself. “I think people are going to read this and start realizing, ‘Wow, it is now an option that I can pick. I can have a taller, smarter, healthier baby,’” he has said.
Especially if such technology is offered for all babies, and not just those conceived by IVF, it could begin to condition parents to think of their children’s value in terms of their desirable genetic traits, or to value this more heavily than they already do.
According to Nucleus’ website, eventually “four out of 10 parents” in the U.S. will use what it calls “genetic optimization” to help their child’s “chances of getting into a top university.” If the technology is reliable and indeed becomes widespread, it could lead to a Brave New World type of scenario in which “carefully selected” and “natural” babies lead to a new class divide.
“Designing a child who would be as unlikely as possible to contract diseases throughout their life and who would therefore have a longer life expectancy is the transhumanist dream of a performance-oriented society where accepting illness and imperfection would seem senseless,” the European Institute of Bioethics noted.
Worst of all, eugenic abortion, which is already being practiced on babies with Down syndrome and other diseases, could become even more prevalent and expand in response to factors like high risk for certain diseases or a predisposition to alcoholism.
Aldous Huxley warned of a Brave New World divided by genetic “class,” but his brother Julian Huxley, an ardent eugenicist who yearned for a “transhumanist” man, may well have welcomed one with open arms. For Julian Huxley, Nucleus IVF+ would be a dream come true.